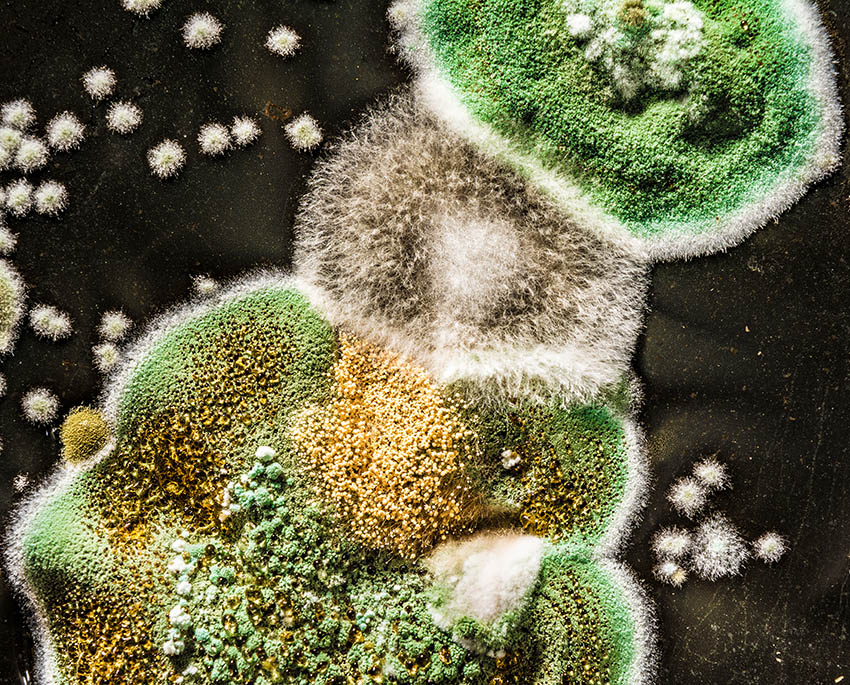
Grönmögel i hemmet kan vara en blandning av flera olika mögelsorter, vilket gör det svårare att identifiera utan en ordentlig analys

Vanligt problem
Grönmögel i hemmet är ett vanligt problem som ofta förväxlas med alger eller andra typer av mögel. Trots att grönmögel kan vara välkänt från vissa matvaror, som blåmögelostar, är det något helt annat när det växer i ditt hem.
Det kan orsaka både hälsoproblem och byggskador, vilket gör det viktigt att förstå vad det är, hur det sprids och hur du ska hantera det.
Vad är grönmögel och var kommer det ifrån?
Grönmögel är inte en enskild art, utan ett samlingsnamn för mögelsvampar som uppträder i gröna nyanser. Många mögelsvampar, som de i släktena Penicillium och Aspergillus, kan uppvisa gröna färger beroende på miljö och tillväxtförhållanden. Grönmögel i hemmet kan också vara en blandning av flera olika mögelsorter, vilket gör det svårare att identifiera utan en ordentlig analys.
Grönmögel växer vanligtvis i fuktiga och dåligt ventilerade miljöer, som källare, kök, badrum eller på vinden. Det är särskilt vanligt att grönmögel förekommer på väggar, tak, fogar eller möbler som har utsatts för fukt under längre perioder.
Är grönmögel farligt för hälsan?
Ja, grönmögel kan vara farligt, särskilt om det är långvarigt och växer i stora mängder. De flesta mögelsvampar, inklusive Penicillium och Aspergillus, utsöndrar mykotoxiner, som är gifter som kan orsaka allvarliga hälsoproblem. Långvarig exponering för dessa toxiner kan leda till:
Det är därför viktigt att omedelbart ta itu med grönmögel och åtgärda orsakerna till fuktproblemet.

Hur kan du ta bort grönmögel i hemmet?
För att tvätta bort grönmögel och förhindra att det återkommer, kan du följa dessa steg:
- Identifiera fuktkällan: Grönmögel uppstår oftast där det finns överskott av fukt. Börja med att hitta och åtgärda eventuella läckage eller dålig ventilation i rummet.
- Använd mögelrengöringsmedel: Det finns effektiva produkter för att ta bort grönmögel, både naturliga och kemiska. Ättika och bikarbonat är bra alternativ för att bekämpa ytligt mögel, medan starkare mögelsaneringsmedel kan vara nödvändiga för mer ingrodd mögel.
- Ventilera och torka: För att förhindra att grönmögel återkommer, bör du säkerställa att rummet är ordentligt ventilerat och torrt. Överväg att använda en avfuktare för att hålla fuktnivån under kontroll.
- Byt ut skadade material: Om grönmöglet har spridit sig i material som trä eller gips kan det vara nödvändigt att byta ut de drabbade ytorna, eftersom mögel ofta tränger djupt in.
För mer detaljer om mögelsanering, kan du kolla in våra mögelsaneringsprodukter.
Hur kan du förebygga grönmögel i ditt hem?
För att förhindra grönmögel i hemmet, här är några viktiga åtgärder:
- Säkerställ god ventilation: Installera och använd ventilationssystem eller badrumsfläktar för att säkerställa att fuktig luft ventileras bort. Öppna fönster regelbundet för att släppa in frisk luft.
- Använd avfuktare: För att hålla luftfuktigheten i schack och förhindra mögeltillväxt kan du använda en avfuktare i fuktiga områden som källare eller badrum.
- Håll ytor torra: Torka av fuktiga ytor, särskilt efter dusch eller bad, för att minska risken för mögelbildning.
- Kontrollera och reparera läckor: Åtgärda eventuella läckage i tak, väggar och rörsystem för att eliminera de källor till fukt som ger mögel möjlighet att växa.
För att hålla koll på luftfuktigheten kan du använda en hygrometer för att mäta nivåerna och se till att de inte överstiger 60 %.

När bör du kontakta en professionell för hjälp med grönmögel?
Om grönmögel har spridit sig till större ytor, eller om du inte kan få bukt med möglet på egen hand, kan det vara dags att kontakta en professionell mögelsanerare. En expert kan hjälpa till att identifiera orsaken till fuktproblemet, sanera möglet på ett säkert sätt och ge råd om långsiktiga lösningar för att hålla ditt hem fritt från mögel.
Vi erbjuder professionell hjälp med mögelsanering i Stockholmsområdet.
Sammanfattning
- Grönmögel är en typ av mögelsvamp som trivs i fuktiga miljöer och kan orsaka hälsoproblem.
- För att ta bort grönmögel kan du använda naturliga rengöringsmedel som ättika eller bikarbonat, samt professionella mögelsaneringsprodukter.
- Förebygg grönmögel genom att säkerställa god ventilation, hålla ytor torra och använda avfuktare.
- Om möglet sprider sig eller återkommer, överväg att kontakta en professionell saneringstjänst.
För att mäta fuktnivåerna i ditt hem och förebygga mögel, kan du använda våra fuktmätare, som finns tillgängliga i vår webbshop.







